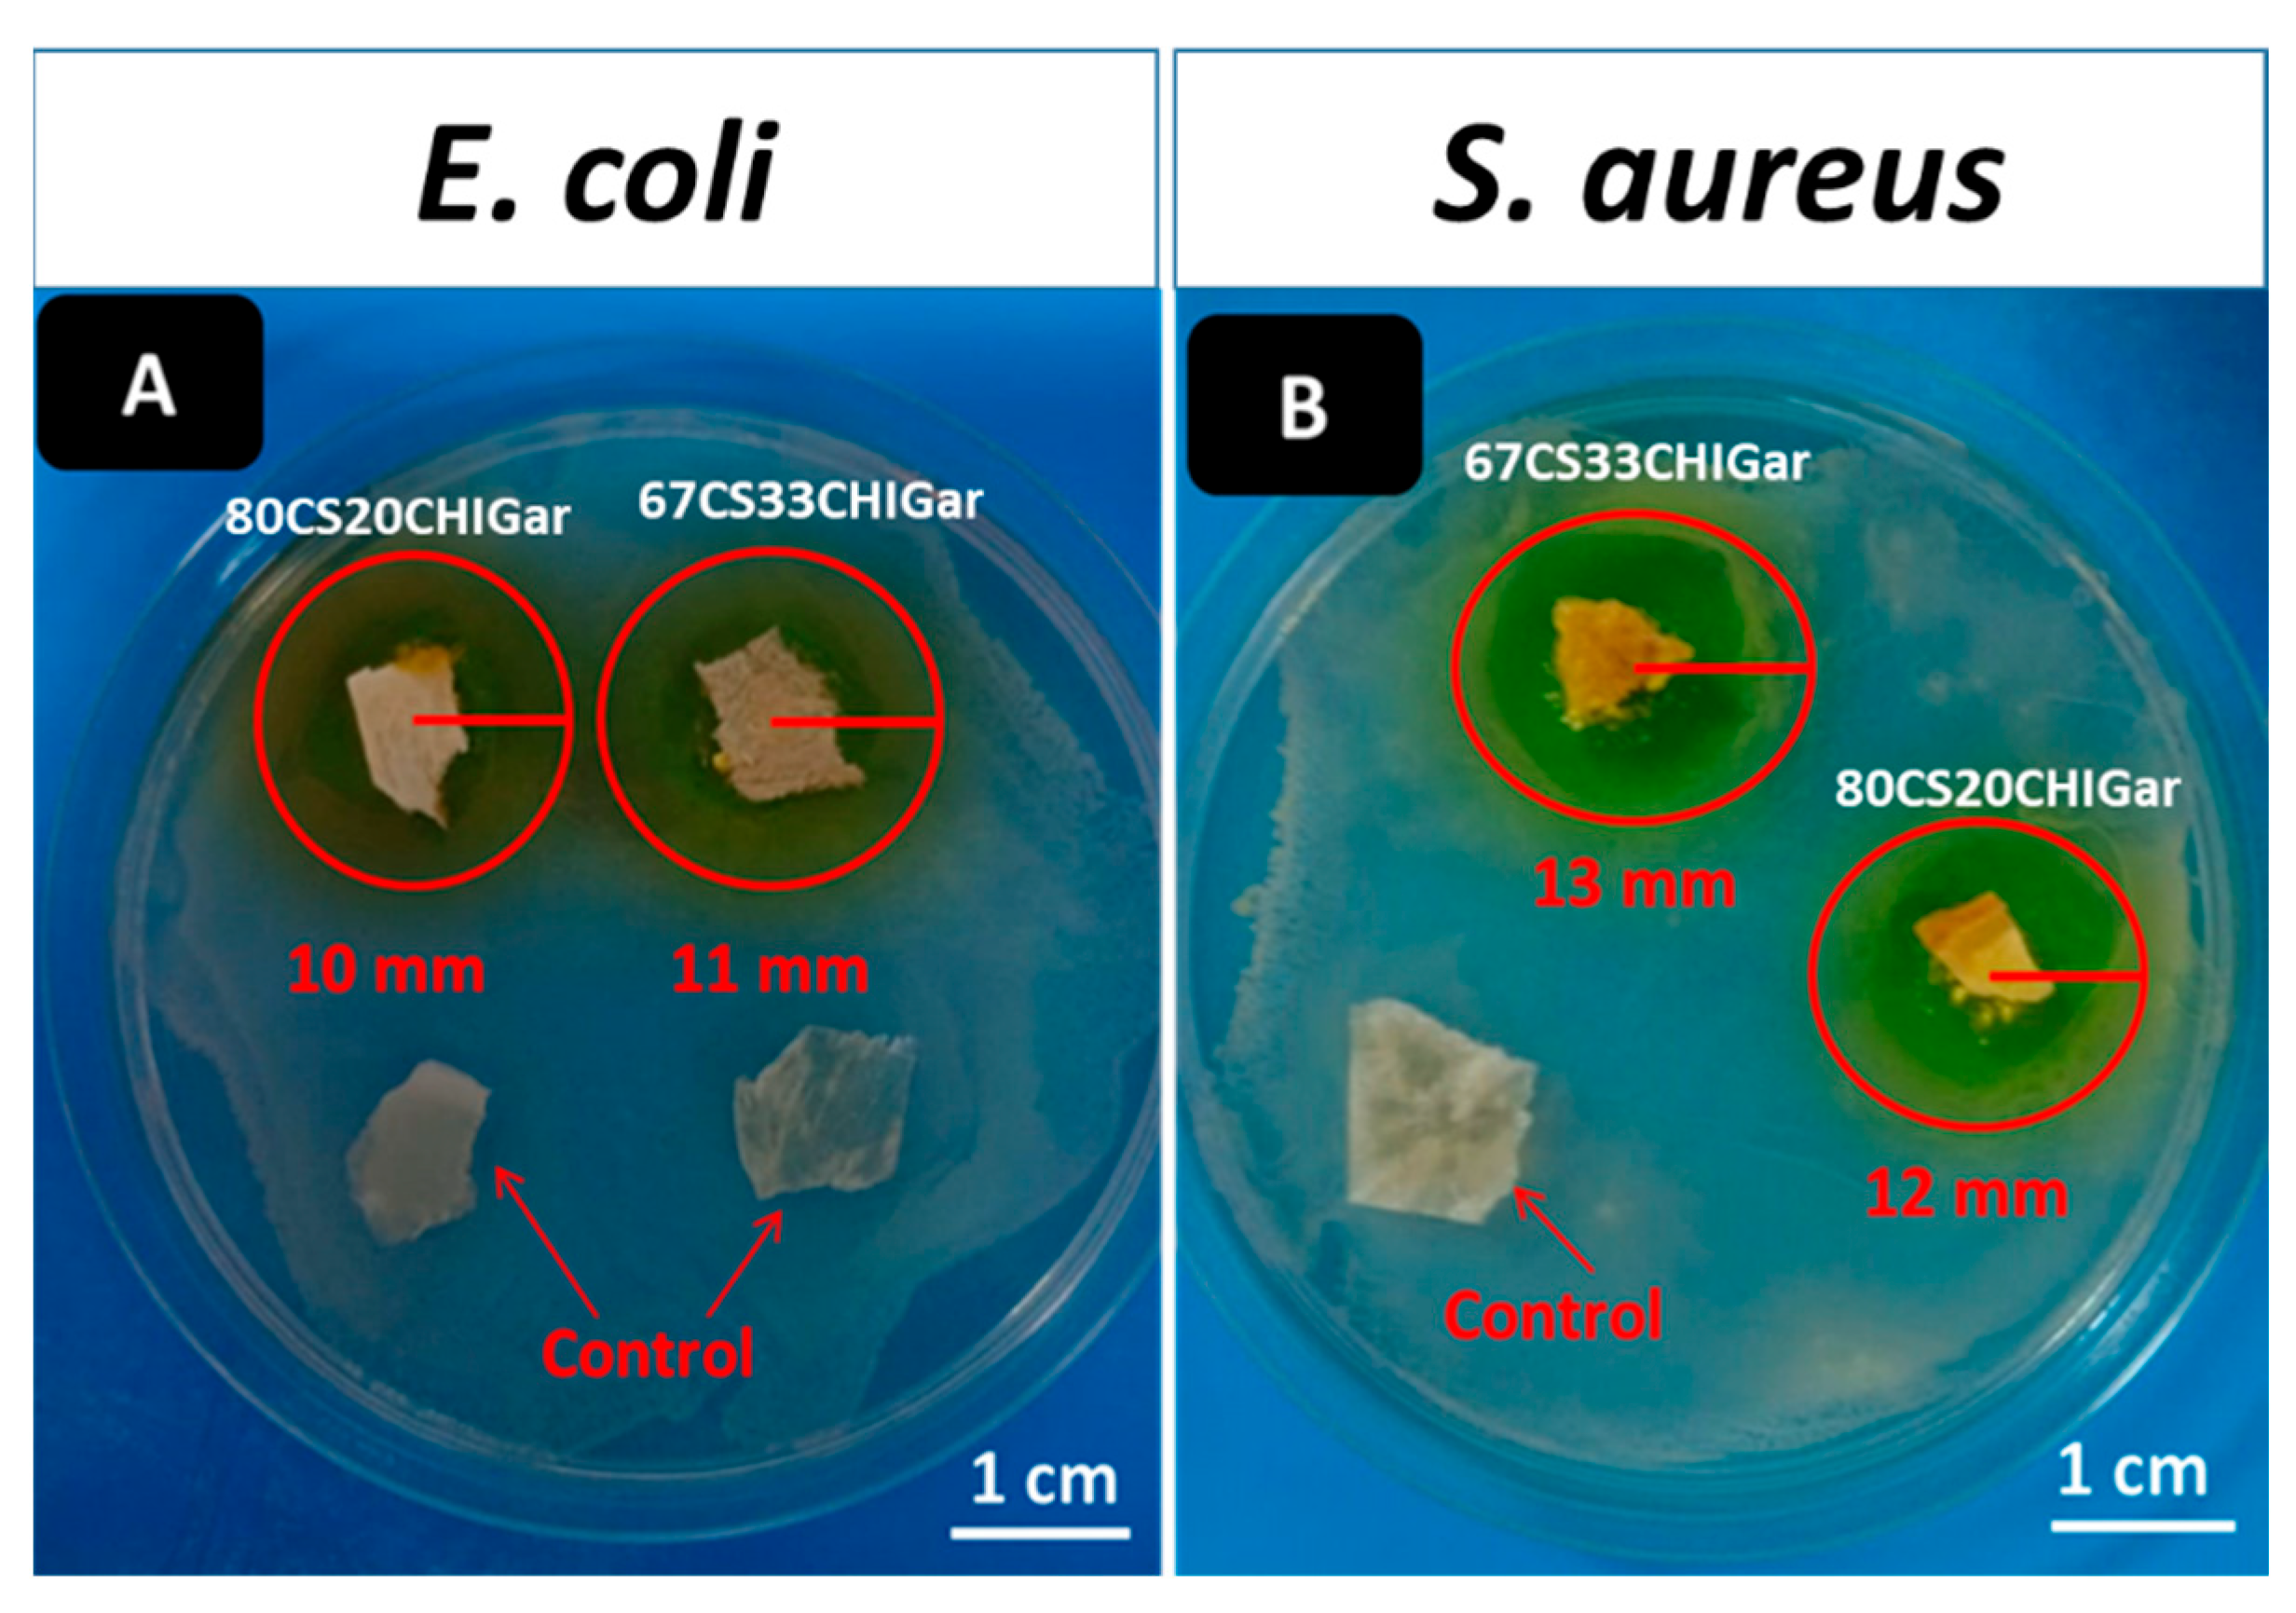
Gels 08 00676 g004 Gels 08 00676 g004

Development and Characterization of Chitosan and Chondroitin Sulfate Based Hydrogels Enriched with Garlic Extract for Potential Wound Healing/Skin Regeneration Applications
Abstract
1. Introduction
2. Results and Discussion
2.1. Morphological Analysis
2.2. FTIR Analysis
2.3. Brunauer-Emmett-Teller (BET) Surface Area Analysis
2.4. Swelling Behavior of Hydrogels
2.5. In-Vitro Degradation Studies
2.6. Antibacterial Analysis of Hydrogels
2.7. Cell Culture Studies
3. Conclusions
4. Experimental Procedure
4.1. Materials
4.2. Synthesis of Hydrogels
4.3. Materials Characterization
4.3.1. Scanning Electron Microscopy (SEM)
4.3.2. Fourier Transformation Infrared Spectroscopy (FTIR)
4.3.3. Brunauer-Emmett-Teller (BET) Surface Area Analysis (Textural Properties)
4.3.4. Swelling Behavior of Hydrogels
4.3.5. In-Vitro Degradation Studies
4.3.6. Antibacterial Analysis
4.3.7. Cell-Culture Studies
4.4. Statistical Analysis
Author Contributions
Funding
Institutional Review Board Statement
Acknowledgments
Conflicts of Interest
References
- Shakespeare, P. Burn wound healing and skin substitutes. Burns 2001, 27, 517–522. [Google Scholar] [CrossRef]
- Cheng, K.; Zhu, Y.; Wang, D.; Li, Y.; Xu, X.; Cai, H.; Chu, H.; Li, J.; Zhang, D. Biomimetic synthesis of chondroitin sulfate-analogue hydrogels for regulating osteogenic and chondrogenic differentiation of bone marrow mesenchymal stem cells. Mater. Sci. Eng. C 2020, 117, 111368. [Google Scholar] [CrossRef]
- Ren, K.; He, C.; Xiao, C.; Li, G.; Chen, X. Injectable glycopolypeptide hydrogels as biomimetic scaffolds for cartilage tissue engineering. Biomaterials 2015, 51, 238–249. [Google Scholar] [CrossRef]
- Liu, H.; Cheng, Y.; Chen, J.; Chang, F.; Wang, J.; Ding, J.; Chen, X. Component effect of stem cell-loaded thermosensitive polypeptide hydrogels on cartilage repair. Acta Biomater. 2018, 73, 103–111. [Google Scholar] [CrossRef]
- Shang, H.; Chen, X.; Liu, Y.; Yu, L.; Li, J.; Ding, J. Cucurbit [7]-assisted sustained release of human calcitonin from thermosensitive block copolymer hydrogel. Int. J. Pharm. 2017, 527, 52–60. [Google Scholar] [CrossRef]
- Gan, D.; Xing, W.; Jiang, L.; Fang, J.; Zhao, C.; Ren, F.; Fang, L.; Wang, K.; Lu, X. Plant-inspired adhesive and tough hydrogel based on Ag-Lignin nanoparticles-triggered dynamic redox catechol chemistry. Nat. Commun. 2019, 10, 1487. [Google Scholar] [CrossRef]
- Khunmanee, S.; Jeong, Y.; Park, H. Crosslinking method of hyaluronic-based hydrogel for biomedical applications. J. Tissue Eng. 2017, 8, 2041731417726464. [Google Scholar] [CrossRef]
- Nam, S.; Hu, K.H.; Butte, M.J.; Chaudhuri, O. Strain-enhanced stress relaxation impacts nonlinear elasticity in collagen gels. Proc. Natl. Acad. Sci. USA 2016, 113, 5492–5497. [Google Scholar] [CrossRef]
- Chaudhuri, O.; Gu, L.; Darnell, M.; Klumpers, D.; Sidi, A.; Weaver, J.C.; Huebsch, N.; Mooney, D.J.; Francisco, S. Substrate stress relaxation regulates cell spreading. Nat. Commun. 2015, 6, 6365. [Google Scholar] [CrossRef]
- Chaudhuri, O.; Gu, L.; Klumpers, D.; Darnell, M.; Bencherif, S.A.; Weaver, J.C.; Huebsch, N.; Lee, H.-P.; Lippens, E.; Duda, G.N.; et al. Hydrogels with tunable stress relaxation regulate stem cell fate and activity. Nat. Mater. 2016, 15, 326–334. [Google Scholar] [CrossRef]
- Guvendiren, M.; Burdick, J.A. Stiffening hydrogels to probe short- and long-term cellular responses to dynamic mechanics. Nat. Commun. 2012, 3, 792. [Google Scholar] [CrossRef]
- Trappmann, B.; Baker, B.M.; Polacheck, W.J.; Choi, C.K.; Burdick, J.A.; Chen, C.S. Matrix degradability controls multicellularity of 3D cell migration. Nat. Commun. 2017, 8, 371. [Google Scholar] [CrossRef]
- Lee, J.-H.; Kim, H.-W. Emerging properties of hydrogels in tissue engineering. J. Tissue Eng. 2018, 9, 2041731418768285. [Google Scholar] [CrossRef]
- Oprea, A.M.; Ciolacu, D.; Neamtu, A.; Mungiu, O.C.; Stoica, B.; Vasile, C. Cellulose/chondroitin sulfate hydrogels: Synthesis, drug loading/release properties and biocompatibility. Cellul. Chem. Technol. 2010, 44, 369–378. [Google Scholar]
- Tsihlis, N.D.; Murar, J.; Kapadia, M.R.; Ahanchi, S.S.; Oustwani, C.S.; Saavedra, J.E.; Keefer, L.K.; Kibbe, M.R. Hydrogels: Methods of Preparation. J. Vasc. Surg. 2010, 51, 1248–1259. [Google Scholar] [CrossRef]
- Lee, C.-T.; Kung, P.-H.; Lee, Y.-D. Preparation of poly(vinyl alcohol)-chondroitin sulfate hydrogel as matrices in tissue engineering. Carbohydr. Polym. 2005, 61, 348–354. [Google Scholar] [CrossRef]
- Wang, L.F.; Shen, S.-S.; Lu, S.-C. Synthesis and characterization of chondroitin sulfate-methacrylate hydrogels. Carbohydr. Polym. 2003, 52, 389–396. [Google Scholar] [CrossRef]
- Kubo, M.; Ando, K.; Mimura, T.; Matsusue, Y.; Mori, K. Chondroitin sulfate for the treatment of hip and knee osteoarthritis: Current status and future trends. Life Sci. 2009, 85, 477–483. [Google Scholar] [CrossRef]
- Comper, W.D.; Zamparo, O. Hydrodynamic properties of connective-tissue polysaccharides. Biochem. J. 1990, 269, 561–564. [Google Scholar] [CrossRef]
- Park, Y.J.; Lee, Y.M.; Lee, J.Y.; Seol, Y.-J.; Chung, C.P.; Lee, S.J. Controlled release of platelet-derived growth factor-BB from chondroitin sulfate-chitosan sponge for guided bone regeneration. J. Control. Release 2000, 67, 385–394. [Google Scholar] [CrossRef]
- Chang, C.H.; Liu, H.C.; Lin, C.C.; Chou, C.H.; Lin, F.H. Gelatin-chondroitin-hyaluronan tri-copolymer scaffold for cartilage tissue engineering. Biomaterials 2003, 24, 4853–4858. [Google Scholar] [CrossRef]
- Flanagan, T.C.; Wilkins, B.; Black, A.; Jockenhoevel, S.; Smith, T.J.; Pandit, A.S. A collagen-glycosaminoglycan co-culture model for heart valve tissue engineering applications. Biomaterials 2006, 27, 2233–2246. [Google Scholar] [CrossRef]
- Fan, H.; Hu, Y.; Zhang, C.; Li, X.; Lv, R.; Qin, L.; Zhu, R. Cartilage regeneration using mesenchymal stem cells and a PLGA-gelatin/chondroitin/hyaluronate hybrid scaffold. Biomaterials 2006, 27, 4573–4580. [Google Scholar] [CrossRef]
- Tan, H.; Chu, C.R.; Payne, K.; Marra, K.G. Injectable in situ forming biodegradable chitosan—Hyaluronic acid based hydrogels for cartilage tissue engineering. Biomaterials 2009, 30, 2499–2506. [Google Scholar] [CrossRef]
- Ushio-Fukai, M.; Nakamura, Y. Reactive oxygen species and angiogenesis: NADPH oxidase as target for cancer therapy. Cancer Lett. 2008, 266, 37–52. [Google Scholar] [CrossRef]
- Taylor, P.; Tangsadthakun, C.; Kanokpanont, S. The influence of molecular weight of chitosan on the physical and biological properties of collagen/chitosan scaffolds. J. Biomater. Sci. 2012, 18, 37–41. [Google Scholar]
- Janvikul, W.; Uppanan, P.; Thavornyutikarn, B.; Krewraing, J.; Prateepasen, R. In Vitro Comparative Hemostatic Studies of Chitin, Chitosan, and Their Derivatives. J. Appl. Polym. Sci. 2006, 102, 445–451. [Google Scholar] [CrossRef]
- Agnihotri, S.A.; Mallikarjuna, N.N.; Aminabhavi, T.M. Recent advances on chitosan-based micro- and nanoparticles in drug delivery. J. Control. Release 2004, 100, 5–28. [Google Scholar] [CrossRef]
- Rajam, K.; Rajendran, S.; Saranya, R. Allium Sativum (Garlic) Extract as Nontoxic Corrosion Inhibitor. J. Chem. 2013, 2013, 743807. [Google Scholar] [CrossRef]
- Borrelli, F.; Capasso, R.; Izzo, A.A. Garlic (Allium sativum L.): Adverse effects and drug interactions in humans. Review 2007, 51, 1386–1397. [Google Scholar] [CrossRef]
- Li, Q.; Yang, D.; Ma, G.; Xu, Q.; Chen, X.; Lu, F.; Nie, J. Synthesis and characterization of chitosan-based hydrogels. Int. J. Biol. Macromol. 2009, 44, 121–127. [Google Scholar] [CrossRef] [PubMed]
- Ji, C.; Annabi, N.; Khademhosseini, A.; Dehghani, F. Fabrication of porous chitosan scaffolds for soft tissue engineering using dense gas CO2. Acta Biomater. 2011, 7, 1653–1664. [Google Scholar] [CrossRef] [PubMed]
- Yannas, I.V.; Lee, E.; Orgill, D.P.; Skrabut, E.M.; Murphy, G.F. Synthesis and characterization of a model extracellular matrix that induces partial regeneration of adult mammalian skin. Proc. Natl. Acad. Sci. USA 1989, 86, 933–937. [Google Scholar] [CrossRef]
- Van De Velde, K.; Kiekens, P. Structure analysis and degree of substitution of chitin, chitosan and dibutyrylchitin by FT-IR spectroscopy and solid state 13C NMR. Carbohydr. Polym. 2004, 58, 409–416. [Google Scholar] [CrossRef]
- Chen, Z.; Cao, S.; Wang, H.; Xuliang, D.; Kishen, A.; Deng, X.; Yang, X.; Wang, Y.; Cong, C.; Wang, H.; et al. Biomimetic remineralization of demineralized dentine using scaffold of CMC/ACP nanocomplexes in an in vitro tooth model of deep caries. PLoS ONE 2015, 10, e0116553. [Google Scholar] [CrossRef]
- Cryogels, B. Studying the Effect of Chondroitin Sulfate on the Physicochemical Properties of Novel Gelatin/Chitosan. Appl. Sci. 2021, 11, 10056. [Google Scholar]
- Garnjanagoonchorn, W.; Wongekalak, L.; Engkagul, A. Determination of chondroitin sulfate from different sources of cartilage. Chem. Eng. Process. Process Intensif. 2007, 46, 465–471. [Google Scholar] [CrossRef]
- Zemlyakova, E.S.; Tcibulnikova, A.V.; Slezhkin, V.A.; Zubin, A.Y.; Samusev, I.; Bryukhanov, V.V. The infrared spectroscopy of chitosan films doped with silver and gold nanoparticles. J. Polym. Eng. 2019, 39, 415–421. [Google Scholar] [CrossRef]
- Babatunde, E.O.; Ighalo, J.O.; Akolo, S.A.; Adeniyi, A.G.; Adepoju, L. Investigation of Biomaterial Characteristics of Chitosan Produced from Crab Shells. Mater. Int. 2020, 2, 303–310. [Google Scholar] [CrossRef]
- Sinha, P.; Datar, A.; Jeong, C.; Deng, X.; Chung, Y.G.; Lin, L.-C. Surface Area Determination of Porous Materials Using the Brunauer-Emmett-Teller (BET) Method: Limitations and Improvements. J. Phys. Chem. C 2019, 123, 20195–20209. [Google Scholar] [CrossRef]
- Kruk, M.; Jaroniec, M. Gas Adsorption Characterization of Ordered Organic−Inorganic Nanocomposite Materials. Chem. Mater. 2001, 13, 3169–3183. [Google Scholar] [CrossRef]
- Ahmadi, F.; Oveisi, Z.; Samani, M.; Amoozgar, Z. Chitosan based hydrogels: Characteristics and pharmaceutical applications. Res. Pharm. Sci. 2015, 10, 1–16. [Google Scholar] [PubMed]
- Chaudhuri, S.D.; Mandal, A.; Dey, A.; Chakrabarty, D. Tuning the swelling and rheological attributes of bentonite clay modified starch grafted polyacrylic acid based hydrogel. Appl. Clay Sci. 2020, 185, 105405. [Google Scholar] [CrossRef]
- Fan, M.; Ma, Y.; Tan, H.; Jia, Y.; Zou, S.; Guo, S.; Zhao, M.; Huang, H.; Ling, Z.; Chen, Y.; et al. Covalent and injectable chitosan-chondroitin sulfate hydrogels embedded with chitosan microspheres for drug delivery and tissue engineering. Mater. Sci. Eng. C 2017, 71, 67–74. [Google Scholar] [CrossRef]
- Aleem, A.R.; Shahzadi, L.; Nasir, M.; Hajivand, P.; Alvi, F.; Akhtar, A.; Zehra, M.; Mehmood, A.; Yar, M. Developing sulfur-doped titanium oxide nanoparticles loaded chitosan/cellulose-based proangiogenic dressings for chronic ulcer and burn wounds healing. J. Biomed. Mater. Res. Part B Appl. Biomater. 2022, 110, 1069–1081. [Google Scholar] [CrossRef]
- Ghandehari, H.; Kopečková, P.; Kopecek, J. In vitro degradation of pH-sensitive hydrogels containing aromatic azo bonds. Biomaterials 1997, 18, 861–872. [Google Scholar] [CrossRef]
- Yang, Q.; Adrus, N.; Tomicki, F.; Ulbricht, M. Composites of functional polymeric hydrogels and porous membranes. J. Mater. Chem. 2011, 21, 2783–2811. [Google Scholar] [CrossRef]
- Zou, X.H.; Jiang, Y.Z.; Zhang, G.R.; Jin, H.M.; Hieu, N.T.M.; Ouyang, H.W. Specific interactions between human fibroblasts and particular chondroitin sulfate molecules for wound healing. Acta Biomater. 2009, 5, 1588–1595. [Google Scholar] [CrossRef]
- Jalababu, R.; Veni, S.S.; Reddy, K.V.N.S. Development, characterization, swelling, and network parameters of amino acid grafted guar gum based pH responsive polymeric hydrogels. Int. J. Polym. Anal. Charact. 2019, 24, 304–312. [Google Scholar] [CrossRef]

| Sample | Average Wet Weight (g) | Average Dry Weight (g) | Difference (g) | Swelling Ratio (%) |
|---|---|---|---|---|
| 67CS33CHI | 9.3865 | 0.3425 | 9.044 | 2641 |
| 80CS20CHI | 12.572 | 0.453 | 12.119 | 2675 |
| Sample | Initial Weight (g) | Weight at Day 21 (g) | Change in Weight (%) |
|---|---|---|---|
| 67CS33CHI | 0.026 | 0.007 | 73 |
| 80CS20CHI | 0.028 | 0.012 | 57 |
| 67CS33CHIGar | 0.012 | 0.001 | 91 |
| 80CS20CHIGar | 0.016 | 0.013 | 18 |
| CS | CHI | Glycerol Solution | Gar | Sample Code |
|---|---|---|---|---|
| 20 mL (66.66%) 0.4 gm/s | 10 mL (33.34%) 0.4 gm/s | 2.5 mL 0.0375 gm/s | 0 | 67CS33CHI |
| 24 mL (80%) 0.48 gm/s | 6 mL (20%) 0.24 gm/s | 2.5 mL 0.0375 gm/s | 0 | 80CS20CHI |
| 20 mL (66.66%) 0.4 gm/s | 10 mL (33.34%) 0.4 gm/s | 2.5 mL 0.0375 gm/s | 5 mL | 67CS33CHIGar |
| 24 mL (80%) 0.48 gm/s | 6 mL (20%) 0.24 gm/s | 2.5 mL 0.0375 gm/s | 5 mL | 80CS20CHIGar |
Publisher’s Note: MDPI stays neutral with regard to jurisdictional claims in published maps and institutional affiliations. |
© 2022 by the authors. Licensee MDPI, Basel, Switzerland. This article is an open access article distributed under the terms and conditions of the Creative Commons Attribution (CC BY) license (https://creativecommons.org/licenses/by/4.0/).
Share and Cite
Masood, F.; Makhdoom, M.A.; Channa, I.A.; Gilani, S.J.; Khan, A.; Hussain, R.; Batool, S.A.; Konain, K.; Rahman, S.U.; Wadood, A.; et al. Development and Characterization of Chitosan and Chondroitin Sulfate Based Hydrogels Enriched with Garlic Extract for Potential Wound Healing/Skin Regeneration Applications. Gels 2022, 8, 676. https://doi.org/10.3390/gels8100676
Masood F, Makhdoom MA, Channa IA, Gilani SJ, Khan A, Hussain R, Batool SA, Konain K, Rahman SU, Wadood A, et al. Development and Characterization of Chitosan and Chondroitin Sulfate Based Hydrogels Enriched with Garlic Extract for Potential Wound Healing/Skin Regeneration Applications. Gels. 2022; 8(10):676. https://doi.org/10.3390/gels8100676
Chicago/Turabian StyleMasood, Fatima, Muhammad Atif Makhdoom, Iftikhar Ahmed Channa, Sadaf Jamal Gilani, Ahmad Khan, Rabia Hussain, Syeda Ammara Batool, Kiran Konain, Saeed Ur Rahman, Abdul Wadood, and et al. 2022. "Development and Characterization of Chitosan and Chondroitin Sulfate Based Hydrogels Enriched with Garlic Extract for Potential Wound Healing/Skin Regeneration Applications" Gels 8, no. 10: 676. https://doi.org/10.3390/gels8100676
APA StyleMasood, F., Makhdoom, M. A., Channa, I. A., Gilani, S. J., Khan, A., Hussain, R., Batool, S. A., Konain, K., Rahman, S. U., Wadood, A., bin Jumah, M. N., & Rehman, M. A. U. (2022). Development and Characterization of Chitosan and Chondroitin Sulfate Based Hydrogels Enriched with Garlic Extract for Potential Wound Healing/Skin Regeneration Applications. Gels, 8(10), 676. https://doi.org/10.3390/gels8100676

